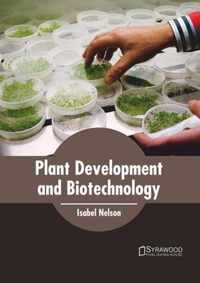
Plant Development and Biotechnology

dormancy and low growth states in microbial disease online kopen
Ben je op zoek naar dormancy and low growth states in microbial disease? Bekijk onze boeken selectie en zie direct bij welke webshop je dormancy and low growth states in microbial disease online kan kopen. Ga je voor een ebook of paperback van dormancy and low growth states in microbial disease. Zoek ook naar accesoires voor dormancy and low growth states in microbial disease. Zo ben je er helemaal klaar voor. Ontdek ook andere producten en koop vandaag nog je dormancy and low growth states in microbial disease met korting of in de aanbieding. Alles voor veel leesplezier!
Dormancy and Low Growth States in Microbial Disease
of infection in a low growth state. This 2003 book addresses the basic science of microbial dormancy and low growth states, putting this in the context;
Vergelijkbare producten zoals Dormancy and Low Growth States in Microbial Disease
Dormancy and Low Growth States in Microbial Disease
of infection in a low growth state. This 2003 book addresses the basic science of microbial dormancy and low growth states, putting this in the context;
Vergelijkbare producten zoals Dormancy and Low Growth States in Microbial Disease
Microbial Threats to Health
the spectrum of microbial threats, factors in disease emergence, and the ultimate capacity of the United States to meet the challenges posed;
Vergelijkbare producten zoals Microbial Threats to Health
Handbook of Microbial Biofertilizers
Sharply focused, up-to-date information on microbial biofertilizersincluding emerging options such as Piriformospora indica and Matsutake;
Vergelijkbare producten zoals Handbook of Microbial Biofertilizers
Handbook of Microbial Biofertilizers
Sharply focused, up-to-date information on microbial biofertilizersincluding emerging options such as Piriformospora indica and Matsutake;
Vergelijkbare producten zoals Handbook of Microbial Biofertilizers
Plant Dormancy
nature, where the hormone promoters and growth inhibitors are balanced. Edaphoclimatic conditions also affect plant dormancy periods, for the;
Vergelijkbare producten zoals Plant Dormancy
The Enteric Microbiota
The human gut is the natural habitat for a diverse and dynamic microbial ecosystem having an important impact on health and disease;
Vergelijkbare producten zoals The Enteric Microbiota
Microbial Threats to Health
the spectrum of microbial threats, factors in disease emergence, and the ultimate capacity of the United States to meet the challenges posed;
Vergelijkbare producten zoals Microbial Threats to Health
Cellular Immune Mechanisms and Tumor Dormancy
Cellular Immune Mechanisms and Tumor Dormancy features the work of internationally recognized experts from various disciplines as they;
Vergelijkbare producten zoals Cellular Immune Mechanisms and Tumor Dormancy
Schaechter's Mechanisms of Microbial Disease
Schaechter's Mechanisms of Microbial Disease provides students with a thorough understanding of microbial agents and the pathophysiology;
Vergelijkbare producten zoals Schaechter's Mechanisms of Microbial Disease
Physiological Models in Microbiology
Physiological Models in Microbiology consists of two volumes. Volume I considers models of basic growth processes and the effects;
Vergelijkbare producten zoals Physiological Models in Microbiology
Physiological Models in Microbiology
Physiological Models in Microbiology consists of two volumes. Volume I considers models of basic growth processes and the effects;
Vergelijkbare producten zoals Physiological Models in Microbiology
Plant Development and Biotechnology
Plant growth occurs in a plant throughout its lifespan. Its growth involves the stages of embryogenesis, organogenesis and cell elongation;
Vergelijkbare producten zoals Plant Development and Biotechnology
Microbial Metabolism and Disease
Microbiome Metabolic Pathways and Disease provides insight into the interaction of microbial metabolic pathways in the human body and the;
Vergelijkbare producten zoals Microbial Metabolism and Disease
Pediatric Nutrition Handbook
very low, and low birth weight infants, full-term infants, children and adolescents; and down syndrome growth charts.;
Vergelijkbare producten zoals Pediatric Nutrition Handbook
Emerging Infections
emergence of microbial threats to health, warns against complacency in public health, and promotes early prevention as a cost-effective and crucial;
Vergelijkbare producten zoals Emerging Infections
Phyto Microbiome in Stress Regulation
advantageous to plant developmental pathways. Gathering contributions by authors with specialized expertise in plant growth and health under;
Vergelijkbare producten zoals Phyto Microbiome in Stress Regulation
Brock Biology of Microorganisms (text component)
Metabolism of Microorganisms, Microbial Growth, Essentials of Molecular Biology, Archael and Eukaryotic Molecular Biology, Regulation of Gene;
Vergelijkbare producten zoals Brock Biology of Microorganisms (text component)
Effect of Spaceflight and Spaceflight Analogue Culture on Human and Microbial Cells
mammalian and microbial cells, how this impacts transition between normal homeostasis and disease, and basic mechanisms of adaptation to low gravity;
Vergelijkbare producten zoals Effect of Spaceflight and Spaceflight Analogue Culture on Human and Microbial Cells
The Nexus Between Economic Growth and Poverty Reduction
could achieve high poverty reduction with low economic growth, while others could achieve low poverty reduction with high economic growth, and;
Vergelijkbare producten zoals The Nexus Between Economic Growth and Poverty Reduction
Microbial Management of Plant Stresses
growth, health and stress resilience Covers all the novel aspects of microbial regulatory mechanism. Key challenges associated with;
Vergelijkbare producten zoals Microbial Management of Plant Stresses
Microbial Endocrinology Interkingdom Signaling in Infectious Disease and Health
the role of microbial endocrinology in the evolutionary symbiosis between man and microbe as it relates to both health and disease. With new;
Vergelijkbare producten zoals Microbial Endocrinology Interkingdom Signaling in Infectious Disease and Health
Composting for Sustainable Agriculture
aerobic to anaerobic form is stated as compost, if added to soil improves plant growth and development. The biological activities and microbial;
Vergelijkbare producten zoals Composting for Sustainable Agriculture
Microbial Communities in Aquaculture Ecosystems
tools to improve water quality, and identifies crucial factors that endanger microbial homeostasis in aquaculture ecosystems. The book also;
Vergelijkbare producten zoals Microbial Communities in Aquaculture Ecosystems
New and Future Developments in Microbial Biotechnology and Bioengineering: Microbial Biofilms
infections, microbial communication during biofilm mode of growth, host defense and antimicrobial resistance, and more. Other sections cover the;
Vergelijkbare producten zoals New and Future Developments in Microbial Biotechnology and Bioengineering: Microbial Biofilms
Einde inhoud
Geen pagina's meer om te laden'